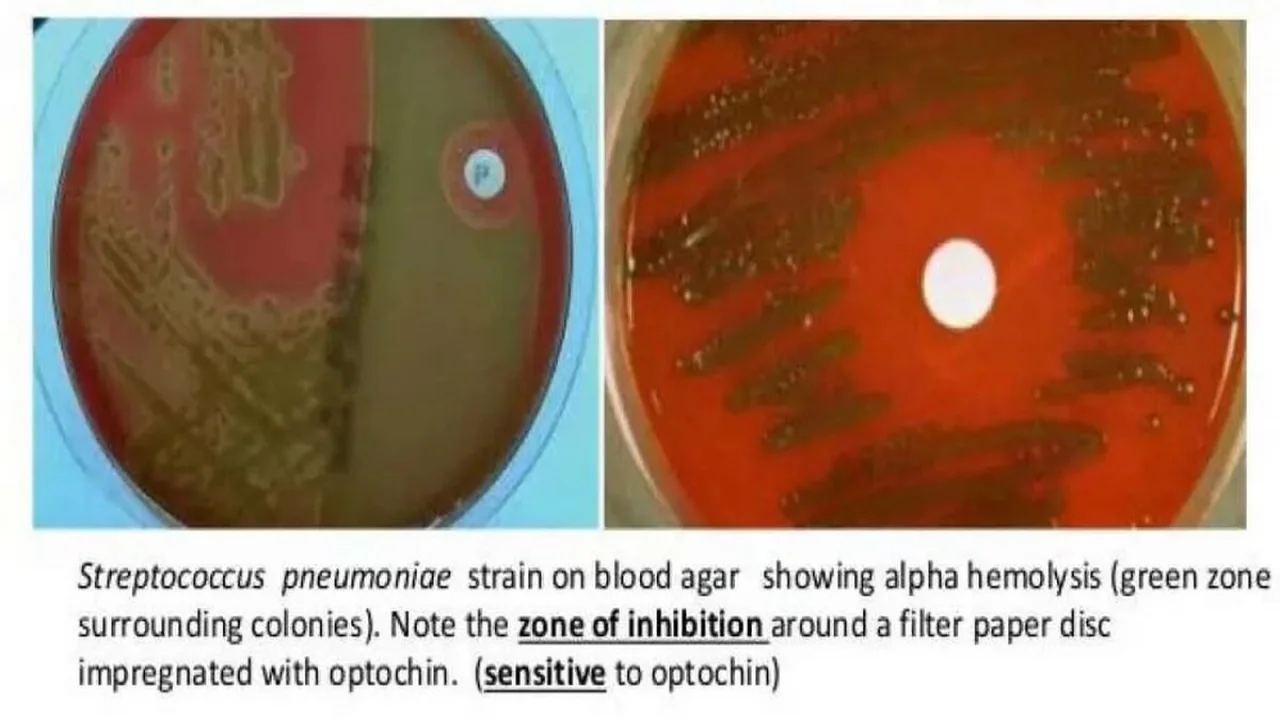

OPTOCHIN DISC TEST
0
Microbiology
OPTOCHIN DISC TEST
To test an organism's susceptibility to the chemical, optochin. Optochin susceptibility tests the fragility of the bacterial cell membrane.
Published:
BS
Login to get unlimited free access
Objective:
To test an organism's susceptibility to the chemical, optochin. Optochin susceptibility tests the fragility of the bacterial cell membrane. This test is mainly used to differentiate between Streptococcus pneumoniae (sensitive) and other Streptococcus species (resistant)
Test Procedure
- Pick a single pure colony with a sterile swab to inoculate a SBA plate. Streak the entire blood agar plate with the swab. Turn plate 90 degrees and re-streak with the same swab. Blood agar plate must be used for optochin testing since all species of Streptococcus are fastidious organisms and require extra enrichment for growth.
- With alcohol flamed forceps, aseptically remove an optochin disc and apply to the center of the plate. Gently apply pressure to disc so that it adheres to the surface of the plate but do not press disc down into the medium.
- Invert plate and incubate for 48 hours at your organism's optimum growth temperature.
Interpretation
- Sensitive (S): A distinct zone of inhibition (5 to 30 mm) with a clear-cut margin around disc.
- Resistant (R): Growth not inhibited around disc.
Precautions
- Occasionally, a few scattered optochin resistant colonies of S. pneumoniae may be observed in a wide zone of inhibition.
- Occasionally an alpha-Streptococcus spp. may exhibit a very small zone (1 to 2 mm) of inhibition. S. pneumoniae exhibits a zone of inhibition at least 5 mm or greater in diameter.
Medically Reviewed
The information on this page is peer reviewed by a qualified editorial review board member. Learn more about us and our editorial process.
Last reviewed on .
Article history
- Latest version
Cite this page:
- Comment
- Posted by Dayyal Dungrela
Tags:
Start a Conversation
Add comment
End of the article